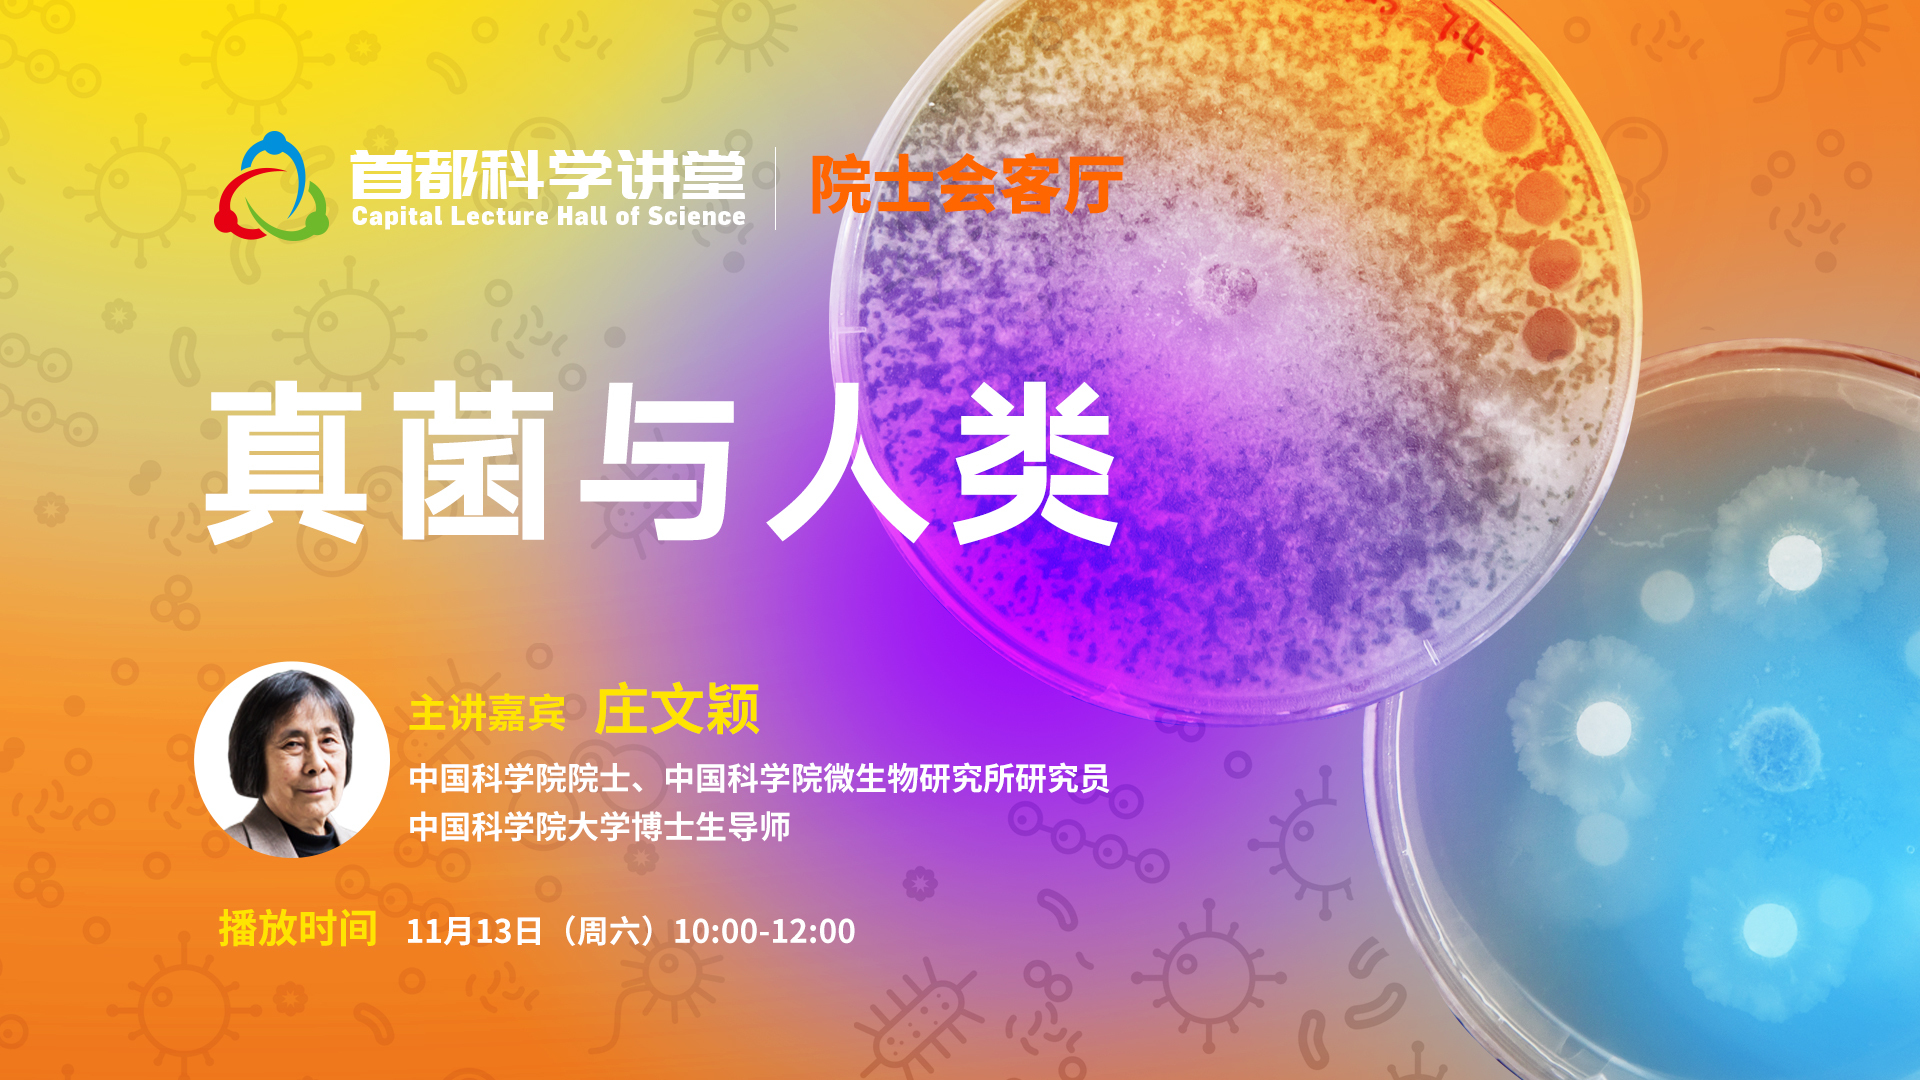
庄文颖院士:真菌与人类 庄文颖院士:真菌与人类

真菌无处不在:它的“足迹”广泛分布于自然界,从平原到高山,从热带到南北两极。它的“家族”门丁兴旺:世界已知约12万种,专家估计总数则约为150万种之多,其数量在生命世界中仅次于昆虫,居第二位。它的“长相”千奇百怪:有的微小到显微镜下才能一觅芳踪,有的体长则能达到1米之巨。这样的真菌,与人类有哪些不得不说的故事? 本期首都科学讲堂之“院士会客厅”特别邀约中国科学院微生物研究所庄文颖院士,带我们了解真菌与人类的密切关系,感受真菌科学的神奇与魅力。


真菌无处不在:它的“足迹”广泛分布于自然界,从平原到高山,从热带到南北两极。它的“家族”门丁兴旺:世界已知约12万种,专家估计总数则约为150万种之多,其数量在生命世界中仅次于昆虫,居第二位。它的“长相”千奇百怪:有的微小到显微镜下才能一觅芳踪,有的体长则能达到1米之巨。这样的真菌,与人类有哪些不得不说的故事? 本期首都科学讲堂之“院士会客厅”特别邀约中国科学院微生物研究所庄文颖院士,带我们了解真菌与人类的密切关系,感受真菌科学的神奇与魅力。


真菌无处不在:它的“足迹”广泛分布于自然界,从平原到高山,从热带到南北两极。它的“家族”门丁兴旺:世界已知约12万种,专家估计总数则约为150万种之多,其数量在生命世界中仅次于昆虫,居第二位。它的“长相”千奇百怪:有的微小到显微镜下才能一觅芳踪,有的体长则能达到1米之巨。这样的真菌,与人类有哪些不得不说的故事? 本期首都科学讲堂之“院士会客厅”特别邀约中国科学院微生物研究所庄文颖院士,带我们了解真菌与人类的密切关系,感受真菌科学的神奇与魅力。
关于北京时间|北京广播电视台&北京新媒体集团&北京网络广播电视台 版权所有|网上传播视听节目许可证0103028号|京ICP备17010175号-1|Copyright © 2026 Btime.com, All Rights Reserved